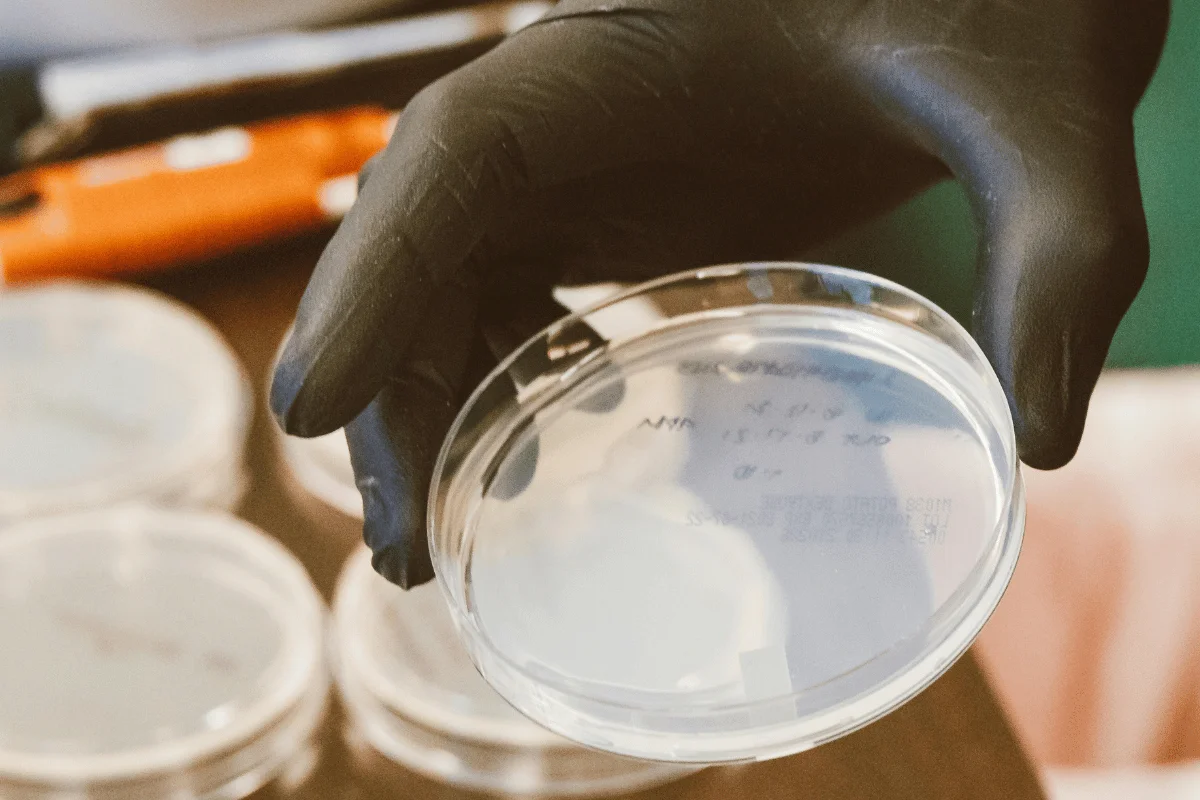
A gloved hand holding a clear petri dish with faint writing, set against a background of similar stacked dishes. The setting conveys a lab environment.

Critical products, such as spacecraft, microchips, pharmaceuticals, sterile medical devices, and high-precision optics, require cleanrooms to prevent contamination that could cause defects or failures.
But keeping cleanrooms free of contaminants is no simple task. It involves far more than wearing proper garments, shutting doors, and following protocols. You must continually track the state of the cleanroom to maintain safety and quality.
This is possible through cleanroom environmental monitoring, which offers insights into the state of your cleanroom. The data empower teams to take actions to prevent particulate contamination and stay compliant.
Below, we explore cleanroom monitoring, including its methods, regulations, challenges, and best practices.
What is Cleanroom Environmental Monitoring?
Cleanroom environmental monitoring involves tracking, measuring, and controlling variables such as microbial contamination, particles, humidity, temperature, and air pressure in a controlled environment. This is vital to ensure the cleanroom meets predefined standards and operates smoothly.
The process includes several methods, including:
- Particulate monitoring
- Microbial monitoring
- Temperature and humidity control
- Airflow and pressure monitoring
- Personnel monitoring
These methods use a network of sensors, particle counters, and software to gather vital data about the cleanroom. Once collected, the data can be analyzed against standards by bodies, such as ISO 14644, GMP, and USP.
The systems also provide real-time alerts and alarms if the data exceeds normal limits, so you can take preventive or corrective actions.

Why Cleanroom Environmental Monitoring is Critical
Cleanroom monitoring helps control contamination, meet ISO/GMP standards, and ensure compliant and safe operations.
The purpose of monitoring is to verify that the facility’s surfaces, air, and systems meet the validated limits for certain products. This way, it supports operational integrity and product safety by detecting microbial and particulate contamination before it impacts production.
Monitoring also helps to identify inefficiencies within the cleanroom systems. For instance, tracking air change rates can tell whether the HVAC units are running optimally, allowing you to implement fixes or replace parts, such as HEPA filters.
The process generates data, which is vital to identifying changes or anomalies and complying with ISO, FDA, and GMP regulations. It also provides historical records for quality control and audits.

Key Parameters in Cleanroom Environmental Monitoring
The parameters you need to monitor in cleanrooms vary depending on the application, product type, and the facility’s ISO classification.
Here are the common parameters facility managers track to secure their environments:
- Temperature: The right temperature is vital for personnel comfort and equipment function. For example, semiconductor cleanrooms require a temperature range of 20 - 22oC.
- Humidity: You need to monitor the room’s humidity level to ensure material stability, prevent static charge, and inhibit microbial growth. It should range between 40 to 60%.
- Particle counts: This measures airborne particles of different sizes to assess the level of air cleanliness, with thresholds of 0.5 µm and 5.0 µm being common.
- Differential pressure: This parameter measures the pressure difference between a cleanroom and adjacent areas, helping prevent cross-contamination. The recommended difference is between 5 and 20 Pascals (Pa).
- Surface cleanliness: Evaluates cleanroom contamination on surfaces like handles, equipment, and workstations.
- Airflow velocity: Tracks the flow and circulation of air in the room to prevent stagnant air pockets and confirm the unidirectional flow required by the cleanroom
- Viable microbial contamination: Assesses the presence of microorganisms in the air and on surfaces using methods such as air sampling, contact plates, and settle plates.
Monitoring these parameters helps you detect deviations from established limits, as well as gather data for continuous improvement.
The recommended limits for these parameters vary based on ISO classification and industry guidelines.

Cleanroom Environmental Monitoring Methods
You can use a range of methods to make sure the environment where they manufacture, test, and store products meets rigorous contamination control standards.
These methods include:
Viable Monitoring
This method helps detect and measure living microbial organisms, such as yeast, fungi, and bacteria, in a cleanroom. It employs sampling and culturing techniques, such as swabs, settle plates, contact plates, and active air samplers.
Conducting the tests allows you to meet and maintain the microbial limit for your ISO classification or GMP grade. For instance, Grade A and ISO 5 cleanrooms have stricter limits, sometimes requiring 0 Colony Forming Units (CFUs) per cubic meter for air and surfaces.
Non-Viable Monitoring
A method for tracking non-living airborne particles, like skin flakes, dust, and fabric fibers. It involves using several techniques, such as particle counting, light scattering, and electrical pulse.
The tests provide a real-time snapshot of a cleanroom’s total particulate loading, allowing your team to prevent product contamination. Also, the presence of non-living particles can indicate failing air filters or non-compliance with protocols.
Surface and Equipment Monitoring
This involves sampling surfaces, such as workstations, handles, and equipment, to check for microbial contamination. You can use contact plates for flat surfaces and swabs for irregular or hard-to-reach areas, such as the undersides of equipment and valve joints.
After collecting the samples, they’re incubated to count CFUs, and the results are compared to the required limits.
Personnel Monitoring
People are the primary source of microbes and particles in cleanrooms, accounting for about 80 to 90 percent of normal microbial organisms. Personnel monitoring helps assess microbial contamination from staff by collecting samples using contact plates on arms and gloves.
Regulatory Requirements and GMP Compliance Standards
Beyond supporting operational integrity and product safety, the cleanroom monitoring methods outlined above support regulatory compliance with various bodies.
Here are the key regulatory requirements and standards you must understand and comply with:
- ISO 14644: This is a series of eight international standards for cleanrooms and controlled environments. It covers classification, monitoring, operations, equipment, cleaning, performance testing, and consumables.
- Current Good Manufacturing Practices (GMP): The FDA’s GMP is a system for ensuring pharmaceuticals are produced and controlled according to quality standards. Failure to comply can result in recall, fines, seizure, or even jail time.
- United States Pharmacopeia (USP) 797: This standard covers the processes and requirements for preparing compounded sterile medications to prevent risks like infection and contamination
These standards focus on preventing contamination, errors, and mix-ups during the manufacturing and preparation of products. This helps protect consumers and ensure high-quality products, while giving you the flexibility to implement necessary controls.
With Moddulx, adhering to these standards is even easier for high-tech industries. Our high-quality modular panels feature aluminum honeycomb cores with uPVC-coated surfaces, providing ample material strength and effective contamination control.
Reach out to our team for modular solutions that simplify monitoring and regulatory compliance.

Best Practices for Cleanroom Environmental Monitoring
Regulatory standards, such as ISO 14644 and GMP, guide the monitoring process based on airborne and surface particle counts. ISO focuses on cleanliness, while GMP focuses on protecting the product during manufacturing.
Whether you’re managing a semiconductor or pharmaceutical cleanroom environment, here are the best practices for monitoring that these standards recommend:
- Create a baseline: Conduct an initial monitoring to understand the room’s typical contamination profile. This allows you to create a baseline for future monitoring.
- Routine monitoring: Perform monitoring regularly, with increased sampling during high-risk activities, such as maintenance.
- Sampling methods: Utilize various sampling methods and techniques, including settle plates and particle counters, to monitor the cleanroom and collect accurate data.
- Data management: Use calibrated cleanroom monitoring equipment to ensure data accuracy and software to track results, sample points, schedules, and reports.
- Incident response: Have clear procedures for responding to incidents and data deviations to implement corrective actions.
In addition to these key practices, your environmental monitoring program must also address other essential elements, such as the selection of sample sites, the duration of monitoring, and defining clear roles for all parties involved in the monitoring process.

Challenges in Cleanroom Environmental Monitoring
Despite the powerful sensors, airflow systems, and HVAC units, monitoring cleanrooms and other controlled environments presents several challenges for facility managers.
The typical hurdles you may face include:
- The human factor: People are the major risk factor in cleanrooms, as they are the main source of microbes and particles. Adequate training is vital to address this challenge.
- Environmental variability: Fluctuations in air pressure, humidity, and temperature can affect monitoring results, making it harder to stay within the required limits.
- Equipment and technology issues: Poorly calibrated equipment produces inaccurate monitoring data, and data integration can be complex when dealing with robust tools.
- Sampling errors: Poor handling, storage, collection, and processing can lead to errors, increasing the risk of missing contamination incidents.
- Regulatory challenges: Facilities must continually adapt to evolving regulations and standards from regulatory bodies, such as GMP and ISO, which can be a significant burden.
A well-designed cleanroom monitoring program can address these challenges, giving you control over viable and non-viable particles to ensure operational integrity.

Frequently Asked Questions (FAQs)
Here are answers to questions that many facility managers ask:
How Does Cleanroom Environmental Monitoring Integrate With HVAC Systems?
Cleanroom environmental monitoring works with HVAC systems through real-time feedback.
This involves sensors that check and report conditions to the HVAC unit, which automatically adjusts parameters, such as air pressure, humidity, and temperature, to maintain the required limits.
The HVAC system filters air, regulates airflow, and manages pressure differentials, while the monitoring system feeds it data to ensure the setup works effectively and meets standards.
How Do You Select the Right Monitoring Vendor?
To select the right cleanroom monitoring vendor, you need to evaluate multiple suppliers based on factors such as:
- Technical expertise
- Product features
- Product support
- Industry specialty and experience
The vendor must have a strong knowledge of key standards like GMP and ISO 14644.
If searching for software, it must be able to generate compliance reports and meet your industry’s compliance needs. For products, such as air samplers, sensors, and particle counters, pay attention to capabilities for data logging and calibration.
What KPIs Are Used to Measure Monitoring Performance?
Key KPIs for measuring cleanroom monitoring performance include temperature, humidity, particle counts, differential pressure, and microbial monitoring results. You can compare this data to your baseline and regulatory limits to gauge performance.
Also, assessing your data quality, compliance rate, and operational efficiency, including equipment uptime and downtime, can provide crucial performance insights.
You can improve performance by setting clear objectives, analyzing data, training personnel, investing in technology, and taking corrective actions.
Conclusion
Controlled environments are essential facilities in high-tech industries like biotech, aerospace, semiconductor, and pharmaceutical. They are crucial for providing a conducive environment for the production, testing, and storage of products, such as sterile devices, food, and cosmetics.
To that end, regular and real-time cleanroom monitoring is necessary to ensure the facility is contaminant-free for safe manufacturing, testing, or storage. Additionally, all parameters, including air pressure, humidity, and temperature, must remain within the validated limits.
At Moddulx, we support effective cleanroom monitoring through quality modular solutions for controlled environments. Our tailored, high-quality panels enhance operational efficiency and hygiene, reducing room for data, analytical, and sampling errors in cleanroom monitoring.
Connect with us today to discover how our custom panel solutions can enhance hygiene and operational integrity in critical environments.
%20(1).jpg)